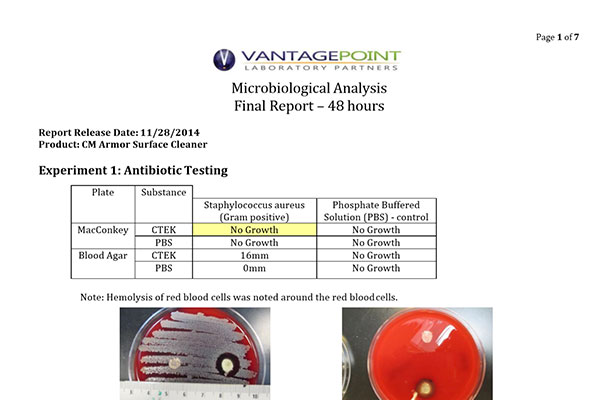

Technical Reports, Case Studies, Plant Trials, Lab Reports and Certifications have been conducted and secured under various alias brand names (e.g. FENZ, AMP, Hedge Defense). CerarMist is a proprietary name that creates a “brand” synonymous with the characteristics and properties of the suite of products that were branded and utilized for the testing, trials and ultimate certifications listed below.